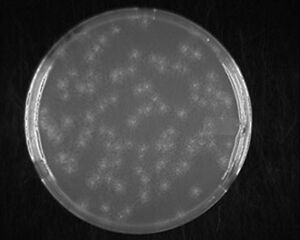

Ampicillin
Mode of Action
Inhibits the formation of cross-links in the peptidoglycan layer (which provides rigidity to the cell wall). Most effective against cells in log phase growth (since this is when new cross-links are being formed), and has little effect on cells in stationary phase.
Mechanism of Resistance
Expression of β-lactamase neutralizes ampicillin. The resistance gene is named bla or ampR. When this enzyme is expressed on a high-copy number plasmid there is significant diffusion into the extracellular medium. As a result non-resistant satellite colonies may form around larger resistant colonies.
Stock Solution
Typical concentrations of ampicillin are 50 μg/mL for low copy plasmids and 100 μg/mL for high copy plasmids. Stock solutions are typically at 100 mg/ml, so that 1 ml of antibiotic can be added to 1 liter of broth or agar. Stock solutions made in 50% alcohol remain liquid at -20°C and are easy to pipet. Cool agar to 55°C or below prior to adding antibiotic.
Ampicillin available from Sigma A-9518 (Ampicillin sodium salt), FW 371.39. To make 100ml of 100 mg/ml stock solution, dissolve 10 g of ampicillin in 50 ml of water and 50 ml of 100% ethanol.
Stability
Culture plates with ampicillin can be stored at 2-8°C for up to two weeks. (In our experience, plates are usable for 2-3 months when stored at 4°C and bagged to prevent evaporation. -tk) Stock solutions may be stored at 2-8°C for up to 3 weeks. For long term storage (4-6 months), stock solutions should be stored at -20°C. At 37°C in culture, ampicillin is stable up to 3 days. Sigma reference
Usage Notes
A 1990 paper by Bill Studier discusses how the secreted β-lactamase can quickly consume all the ampicillin in a culture (even at 20μg/ml Amp). A stationary culture of ampicillin resistant cells can have such a concentration of β-lactamase that even a 1/200 to 1/1000 dilution will still contain enough β-lactamase to consume all the fresh ampicillin before all the non-resistant cells from the stationary phase culture have been killed. The authors recommend not allowing cultures to reach stationary phase if you need a high proportion of cells to contain your plasmid.
- Barry Canton & Matt Gethers have seen this occur when using the BioBrick plasmid, pSB1A3 expressing a high level of mCherry.
Carbenicillin is much more resistant and would be preferred except for cost. Mixtures of ampicillin and carbenicillin are often used.
References
- ANDERSON ES and DATTA N. RESISTANCE TO PENICILLINS AND ITS TRANSFER IN ENTEROBACTERIACEAE. Lancet. 1965 Feb 20;1(7382):407-9. DOI:10.1016/s0140-6736(65)90004-8 |
- Datta N and Richmond MH. The purification and properties of a penicillinase whose synthesis is mediated by an R-factor in Escherichia coli. Biochem J. 1966 Jan;98(1):204-9. DOI:10.1042/bj0980204 |
- Evans J, Galindo E, Olarte J, and Falkow S. Beta-lactamase of R factors. J Bacteriol. 1968 Oct;96(4):1441-2. DOI:10.1128/jb.96.4.1441-1442.1968 |
- ISBN:0-87969-577-3